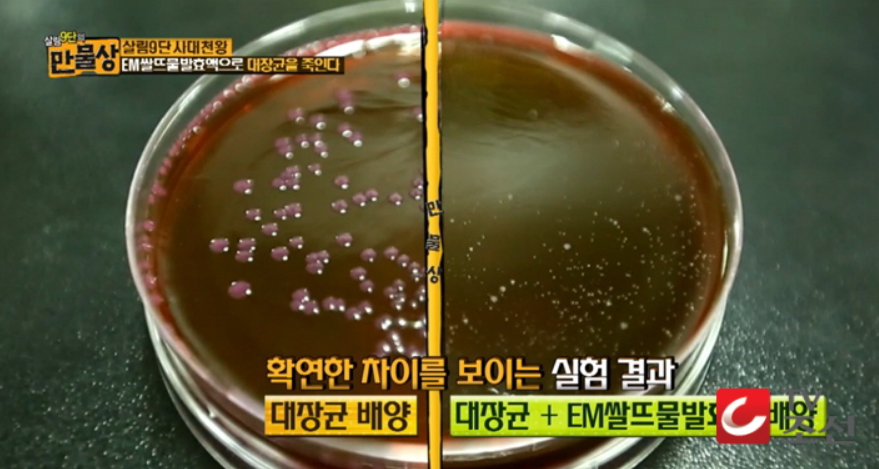

em발효액 만들기,만물상 em쌀뜨물 발효액 만들기,em발효액 활용법/사용법
em발효액 만들기
EM(이엠)이란?
EM은 "Effective Microorganisms"의 약자입니다. 유용미생물군으로 해석합니다.
이 세상의 모든 미생물 중에 인간과 환경 등에 무해하고 좋은 역할과 기능을 하는 미생물들을 복합 배양한 것을 EM이라고 합니다.
EM의 가장 큰 특징은 항산화력입니다. 유산균은 요구르트나 김치를 발효하는데 큰 역할을 하는 유용한 미생물이고, 효모는 빵을 발효시키는데, 방선균은 토양을 비옥하게 하는 등 이러한 미생물들을 복합 배양함으로서 우리 인간에게 유용하고 환경을 자연치유하게 하는 것입니다. 이 미생물들은 각기 서로 다르지만, 같은 환경에서 서로 공존 공영하는 발효를 통해 항산화력이 강한 물질을 뿜어내게 됩니다. 이 항산화력이야말로 EM의 가장 큰 효능이라 할 수 있습니다.
EM의 항산화력을 이용하여 실생활에 적용한 예는 많습니다. 예를 들면, 하천의 수질정화(실제 분당의 탄천이나 서울의 홍제천 울산의 태화강 등 많은 지방자치단체에서 EM으로 수질정화사업 실시하였음), 건축에서 EM사용으로 부식 및 산화방지(EM세라믹, EM활성액 사용으로 건축시 실제 사용), 가정에서는 음식물쓰레기 발효 후 퇴비사용, 욕실청소, 설거지, 빨래, 청소 등의 다목적으로 사용하고 있으며, 농축수산 업자들도 음수로 먹이거나 생균제로서 가축에 먹이거나 양만장과 같은 곳에서 실제하고 있다.
EM은 식품인가 비료인가?
원액중에는 식품인지(먹을수 있는지) 비료인지 잘 알아보고 구별하기em원액을 이용한 em 쌀드물 발효액 만들기 열풍이 불고 있네요.tv조선 만물상 쌀뜨물 발효액 만들기 및 사용방법이 소개되면서 em발효액 및 쌀뜨물 발효액 만들기에 대한 관심이 크게 높아지고 있습니다 한국에서 만든 정품 한국 em원액은 식품 입니다 em미생물들을 이용한 비료는 일본이 먼저 만들어 생산하였습니다
한국에서는 em미생물들을 한국의 전통 발효식품의 미생물들을 이용하여 식품으로 만들었습니다
em원액은 비료와 식품이 있는데 식품용 EM원액은 분말형태로 만들어지고 있습니다.
이는 액상일 경우 규격화하기에 곤란하다는 점 때문이라고 합니다.
식품은 생산할 당시와 유통기한 내에는 규격화된 상태와 미생물들의 성장 및 기타 작용을 정지해 놓아야 하는데 미생물들은 살아있는 생명체 이기 때문에 액상 상태에서는 안전성을 확보하기 어렵기 때문에 em원액 식품은 분말로된 것이라고 합니다
em쌀뜨물 발효액 만드는 법
쌀뜨물 1리터(1.5리터) + 설탕 10g(15g)이상 + EM 10cc(15cc)이상

쌀뜨물발효액 만들기
- 준비물 : 쌀뜨물, EM원액, 설탕, 페트병
1. 신선한 쌀뜨물을 세척된 페트병(1.5L)에 담으세요.(윗쪽에 4~5cm정도 공간을 남겨두세요)
(겨울에는 쌀뜨물을 미지근하게 데운 후에 사용하세요)
2. 설탕 15~20g, EM원액 15~20g을 넣고 페트병 뚜껑을 닫고 흔들어서 잘 섞어주세요.
(EM원액은 조금더 넣어도 되며, 설탕은 백설탕, 물엿, 당밀 모두 가능합니다)
3. 뚜껑을 완전히 밀봉하고 직사광선을 피해서 따뜻한(20~40℃) 곳에서 일주일정도 보관하세요.
4. 백설탕을 사용하면 노란빛을 띠는 발효액이 되는데, 시큼하고 막걸리 냄새와 비슷하게 됩니다.
(악취가 난다면 실패한 것입니다.)
5. 냄새를 좋게 하기 위해서 녹차잎등의 허브를 첨가해도 좋습니다.
6. 완성된 발효액은 되도록 빠른 시일내에 사용하는 것이 좋습니다.
(발효액의 보관.사용중에 악취가 난다면 사용을 중지하세요)
쌀뜨물 대신에 우유나 살겨우려낸물.국수삶은물을 사용해도 된다
하루에 한번씩 흔들어 주면 발효가 더욱 빨리 진행된다고 합니다.
EM 발효액은 혐기성(산소가 없는 곳에서 생육하는 ) 미생물이라 반드시 밀봉합니다.
2~3일 마다 한번씩 가스를 빼 주지 않으면 패트병이 팽창하여 터지는 수가 있습니다.
미생물이 최적 활동 온도는 25~30도이고, 생육 온도는 12~45도입니다.
여름에는 일주일 정도 겨울에는 보름 이상 걸려야 발효가 완성됩니다.
설탕은 미생물을 위한 밥일 뿐입니다. 색과 종류는 상관이 없습니다.
설탕이나 EM 원액의 첨가 비율을 정확히 지키지 않아도 발효 과정에는 별 차이 없습니다.
위에 나온 설탕의 용량은 최소 용량입니다. 펫트병 뚜껑 3~4개 용량이거나 그 이상도 상관 없습니다. EM 원액을 많이 넣을 수록 발효도 빨리 진행됩니다. 사람으로 치자면 EM 원액은 일꾼. 설탕과 살뜨물은 밥으로 보시면 됩니다.
쌀뜨물 이외에 다른 종류를 첨가해도 됩니다. 다만 색이 있는 발효액으로 희석한 액체를 옷에 분무시 옷이 물들 수도 있습니다.
꼭 1.8리터 페트병 용기여야 하는 이유는 없습니다.
찬물보다 미지근한 물로 하는 것이 발효에 더 좋습니다.
쓰던병을 다시쓰면 발효가 더 잘 됩니다.
쌀뜨물을 EM으로 발효시키면 정화원으로 바뀌는 이유?
쌀뜨물을 EM으로 발효시키면 쌀뜨물에 있는 고분자의 탄수화물, 단백질, 지방 등이 유용미생물이 생성하는 여러 가지 효소[아밀라제(Amylase), 프로테아제(Protease), 리파아제(Lipase) 등]에 의하여 저분자의 아미노산, 당류, 유기산, 항산화물질로 전환되며 발효분해계의 유용한 미생물(효모, 유산, 광합성 세균 등)이 증가하게 된다. 따라서 이 발효액을 흘려보내면 자연계의 생물(미생물)과 연동하여 썩은 오니를 분해시키며 유기산과 항산화 물질이 악취를 제어하고 비이온화 작용을 하므로 훌륭한 정화제로서 기능을 하게 되는 것이다.
EM 쌀뜨물 발효액 활용법(사용법)-희석비율
1. 발효되면서 항산화물질과 각종 효소, 미네랄 생성된 미생물을 쓰면서 환경 살리기
- 원리 : 호기성, 염기성, 광합성 미생물이 공존하면서 쌀뜨물(우유물)과 당밀(흙설탕)을 먹고 서로 부산물을 먹이 로 상생하면서 발효가 이루어지고 각종 미네랄과 비타민, 아미노산을 형성하고 적재적소에서 항산화작용을한다. 물과 땅과 식물, 동물의 세포 속에 과다한 활성 산소를 산화(노화)를 억제하면서 환원시키고 다시 살리는 작용을 한다.
- 응용 범위 : 농수축산업, 의학, 공학, 원예, 음식쓰레기 자원화, 재생되는 피부조직 재생
- 원칙 : 공기, 흙, 물에는 1주일 정도, 피부는 10분간 미생물이 살 수 있을 때 까지 사용
2. 피부에 사용
- 모기 물렸을 때:2-3번 바르면 가려움이 없이지고, 붉은 염증, 물린 흔적도 서서히 없어짐.
- 생마로 생긴 옻:가렵고 따갑고 벌건 얼굴에 즉시 바르면 10분 내로 맑은 피부로 개선 하루 지나서 가려움이 심해질 때부터 매일바르면 각질이 벗어지고 1주일 정도 걸림.
- 피부 트러블 : 발효액 적신 솜을 20-분 붙였더니 각질이 제거되고 부드러워짐.
- 파마, 염색 : 약에 페트병뚜껑 2~3개의 발효액을 넣어 염색, 파마하면 두피 따가움 없음 머리감을 때 듬뿍 섞어서 헹구고 두피에 바르면 부작용 해소
- 아토피, 습진 : 스킨처럼 수시로 바른다. 가려움증은 없어지고, 점점 심해지는 호전 반응을 보이면서 코끼리등 껍질처럼 딱딱해짐. 이때 알칼리수온천등에서 자연스럽게 껍질을 벗겨지도록 유도. 껍질이 벗겨 지면서 아토피에 상처등이 점점 아물어 가는 것을 볼수 있다. 가려움증은 화장솜에 묻혀서 10분이상 올려 놓으면 상처가 없어진다. 건조한 날씨에 바람맞아 얼굴이 벌겋게 될 때도 발효액을 타서 화장솜으로 발라주면 피부가 맑게 가라않고 부드럽다.
- 여드름, 수술 후 꿰맨 자극상처회복 : 솜에 묻펴 아침저녁으로 화장솜으로 닦아내니 여드름은 짜지 않아도 없어 지고 수술 부기가 가라 않고 회복
- 종기, 화농 : 10분 정도 연속 바르면 누런 고름이 딱지 않았다 2일후 떨어진다.
- 환절기에 발 바닥이 갈라지는 경우 : 발효액을 발바닥에 적셔 비닐봉지 싸고 양말을 신고 잠자기를 2번 하 였더니 매끈매끈해짐, 스프레이해도 부드러워짐
- 세수하고 목욕할 때 : 마지막 헹굼에 쌀뜨물 발효액을 타서 쓰면 피부가 부드럽다
- 여성 청결제, 좌욕제로 사용 : 발효액을 물에 타서 사용--종기까지 사라짐.
- 머리 감을 때 : 샴푸액에 발효액 섞어 쓰거나 발효액으로 헹구면 영양제 없이도 머리결이 부드러워진다. 3번째 헹굼물에 섞어 3개월 하니 모발이 굵고 건강해진다.
- 어린이 목욕 세제 : 세제의 1/3을 쌀뜨물 발효액으로 섞어 쓴다.
*어린이 인형이나 입에 대는 것 : 3시간 이상 발효액에 담군 후 말려서 사용
- 양치 : 치약과 발효액 섞어 두고 사용, 양치 때 발효액을 입에 머금었다가 양치
- 구취(입냄새), 발냄새 : 자주 입에 머금었다가 양치질, 발효액으로 헹구고 바름
- 알레르기비염, 코나 목이 감기로 따가울 때 : 코에 넣어 입으로 뱉어내거나 솜에 묻혀 1시간 코속에 넣었다 뺀다. 목에 자주 뿌려 주면 개운해 짐.
- 치질 : 뒷물할 때 물에 타거나 환부에 바르면 통증 완화, 개선을 느낄수 있음.
- 무좀과 발 , 겨드랑이, 머리 냄새 : 발효액을 하루에 5-6번씩 덧바름, 꾸준히 사용하고 옷과 양말 발효액 물로 헹구고 식생활 개선하면 냄새원인균 활동 정지
3. 요리에 사용
- 청국장, 요구르트 : 삶은 콩, 우유에 발효액, 메주 띄울 때 발효액 뿌려 빠르고 맛 발효.
- 매실액 발효, 포도주 만들때, 간장 담글 때 메주를 발효액 섞은 물에 씻거나 소금 물 4리터에 발효액 120ml를 섞는다.
- 육류, 생선 : 발효액 넣어 냉장보관하거나 밑간할 때 사용하면 맛 좋아짐
- 야채, 과일 씻기 : 희석시킨 물에 10~20분 담궜다가 씻으면 맛, 신선도, 영양 증가
- 소스에 사용 : 소스 만들 때 집간장과 섞어서 요리, 와사비 간장 등, 셀러드 드레싱, 만두나 동그랑 땡, 김 밥 만들 때 고기 비린내 제거와 신선도, 맛 좋게.
- 갈변 방지 : 과일 깎아 두었을 때, 감자, 연근.
- 초절임 :초고추장, 초절임 만들 때 식초량을 줄이고 같이 섞어서
- 어떤 음식이나 너무 짜거나 냄새가 안 좋을 때 약간만 섞으면 맛이 좋아진다.
4. 빨래 부분에 사용
- 헹굼시 : 마지막 헹굼에서 발효액 넣어 헹구면 거품이 분해되어 나오지 않음.
- 세탁기 : 물에 세제를 넣거나 비누를 빨래에 문지르고 발효액을 붓고 최소한 3-6시간이상 담궜다가 (더러우면 5시간) 돌리면 흰색 옷, 겉옷이 많이 깨끗하게 세탁됨.
- 찌든 커튼 세탁 : 발효액 희석액에 하루 담궈둔 후 세제를 넣어 조금만 밟아줘도 때가 쏙빠져 새커튼이 됨.
- 핏물 얼룩 : 마른 핏물에 발효액을 뿌리고 문질러 분해시켜 비누칠하여 빤다.
- E.M. 가루비누로 세탁 : 발효액으로 만든 EM비누를 강판에 갈아 세탁기에 넣으면 세탁 거품이 많이 나고 예 전처럼 여러 번 헹구지 않아도 거품이 빨리 제거됨.
*어린이 인형이나 입에 대는 것 : 3시간이상 발효액에 담군 후 말려서 사용
5. 냄새, 곰팡이, 박테리아 제거( 주로 300분의 1로 희석)
- 가죽장갑에 곰팡이 : 안팎으로 발효액을 스프레이하고 말려 곰팡이와 냄새 제거
- 마루 돗자리, 장롱, 신장에 곰팡이 제거 : 곰팡이에 발효액을 넣은 스프레이로 뿌려가며 걸레질하면서 곰팡 이와 냄새가 제거되고 반질반질 윤기가 남.
- 김치통 냄새 제거 : 김치통이나 음식물 냄새가 밴 그릇 등에 발효액을 스프레이로 뿌리고 10분 후 설거지 하면 냄새가 없어진다.
- 냉장고 청소 : 발효액으로 청소하면부패균 없이 음식물 저장 기간 증가
- 화장실, (특히 남자화장실) 냄새 제거 : 발효액만 뿌리거나 비누물과 함께 사용하면 냄새가 제거 된다.
- 토끼, 햄스터, 강아지 : 발효액 물에 타서 집에 뿌려서 냄새 없애고 부산물(똥) 퇴비화.
- 장마철 쌀에서 나쁜 냄새가 날 때 : 쌀 마지막 씻을 때 발효액으로 헹궈준다.
- 노인 방, 오물 묻은 옷 냄새 : 방청소시 스프레이에 발효액을 넣어 뿌려가면서 방을 닦아내고 옷에 뿌려 세 탁하거나 헹구어 뿌리면 냄새 제거됨.
- 음식물쓰레기 : 음식물을 버릴 때 쌀뜨물 발효액을 뿌려주면 악취없이 사료화
- 하수구,싱크대 냄새 제거 : 하수구, 싱크대 쌀뜨물 발효액으로 냄새 제거.
- 도마에 비린내나 냄새가 심한 음식을 조리한 후 냄새제거는 물론 살균효과
- 각종세제와 섞어쓰기 : 주방세제, 목욕세제, 헤어샴푸, 린스 등 각종세제에 쌀뜨물 발효액을 1/2내지 1/3 정도 섞어 쓰면 세제의 독과 하수구 오염이 줄어든다.
- 장마철 화장실 하수구에 잠자기 전 발효액 1.5리터 부으면 며칠동안 냄새 안남.
6. 꽃, 야채, 물고기 가르기( 1,000분의 1로 희석)
- 야채 가꾸기 : 야채밭에 20리터 물에 발효액 100ml을 연하게 타서 야채에 1주일에 한번 정도 뿌려주면 벌 레를 쫓고 살균효과와 야채에 영양공급
- 물고기 기르기 : 물에 1/1000 비율로 약하게 섞어 주면 물 맑고 면역성 증가
em발효액 보관방법
EM원액은 상온에서 6개월정도 보관이 가능하며 뚜껑을 단단히 닫아서 보관하셔야 합니다.
뚜껑을 자주 열고 닫으면 보관기간이 짧아질 수도 있습니다.
상온보관(15~40℃)이 원칙이며, 냉장보관시에는 활성이 감소하여 효과가 떨어집니다.
만물상 em쌀뜨물 발효액 만들기

EM 쌀뜨물 발효액 만들기
만물상 TV 프로에 EM 효소 EM 원액 em 발효액 만드는법 em원액만드는법 em쌀뜨물발효액만드는법이 소개되었는데요,
.EM 쌀뜨물 발효액 은 대장균 살균 효과가 있다고 tv조선 살림 9단의 만물상 김원희 프로그램에서 소개되었습니다.
em원액 em 쌀뜨물 발효액 만드는법 입니다.
준비물:
EM 원액 또는 식용 em 원액 분말, 당밀 또는 설탕, 천일염, 페트병, 쌀뜨물
쌀뜨물 1.8리터 페트병에 식용 EM 원액 분말 1g + 천일염 1g + 설탕 60g(밥주저 6개) 넣고 잘 섞이도록 흔들어 뚜껑을 꼭 닫고 7일 정도 발효해 주면em 쌀드물 발효액 만들기 완성
* 잠깐 식용 em원액 분말 식품용은 발효가 em원액 액상보다 빠르기 때문에 용기를 만져 가스가 빵빵하게 차있으면 뚜껑을 살짝 열고 가스를 빼주시기 바랍니다.
'유기농&친환경농법' 카테고리의 다른 글
| 진딧물 없애는 방법 (0) | 2021.05.10 |
|---|---|
| 천연 액비 만들기/액비 만드는 법 (0) | 2021.05.07 |
| 난황유 만들기,난황유 진딧물 방제 만드는법 (0) | 2021.03.27 |
| 천연 해충 퇴치(기피) 식물 10종,벌레나 해충을 쫒는 허브 나 식물 (0) | 2021.03.27 |
| 작물혼작(동반) 작물 재배법,상생 상극 작물 (0) | 2021.03.26 |
댓글